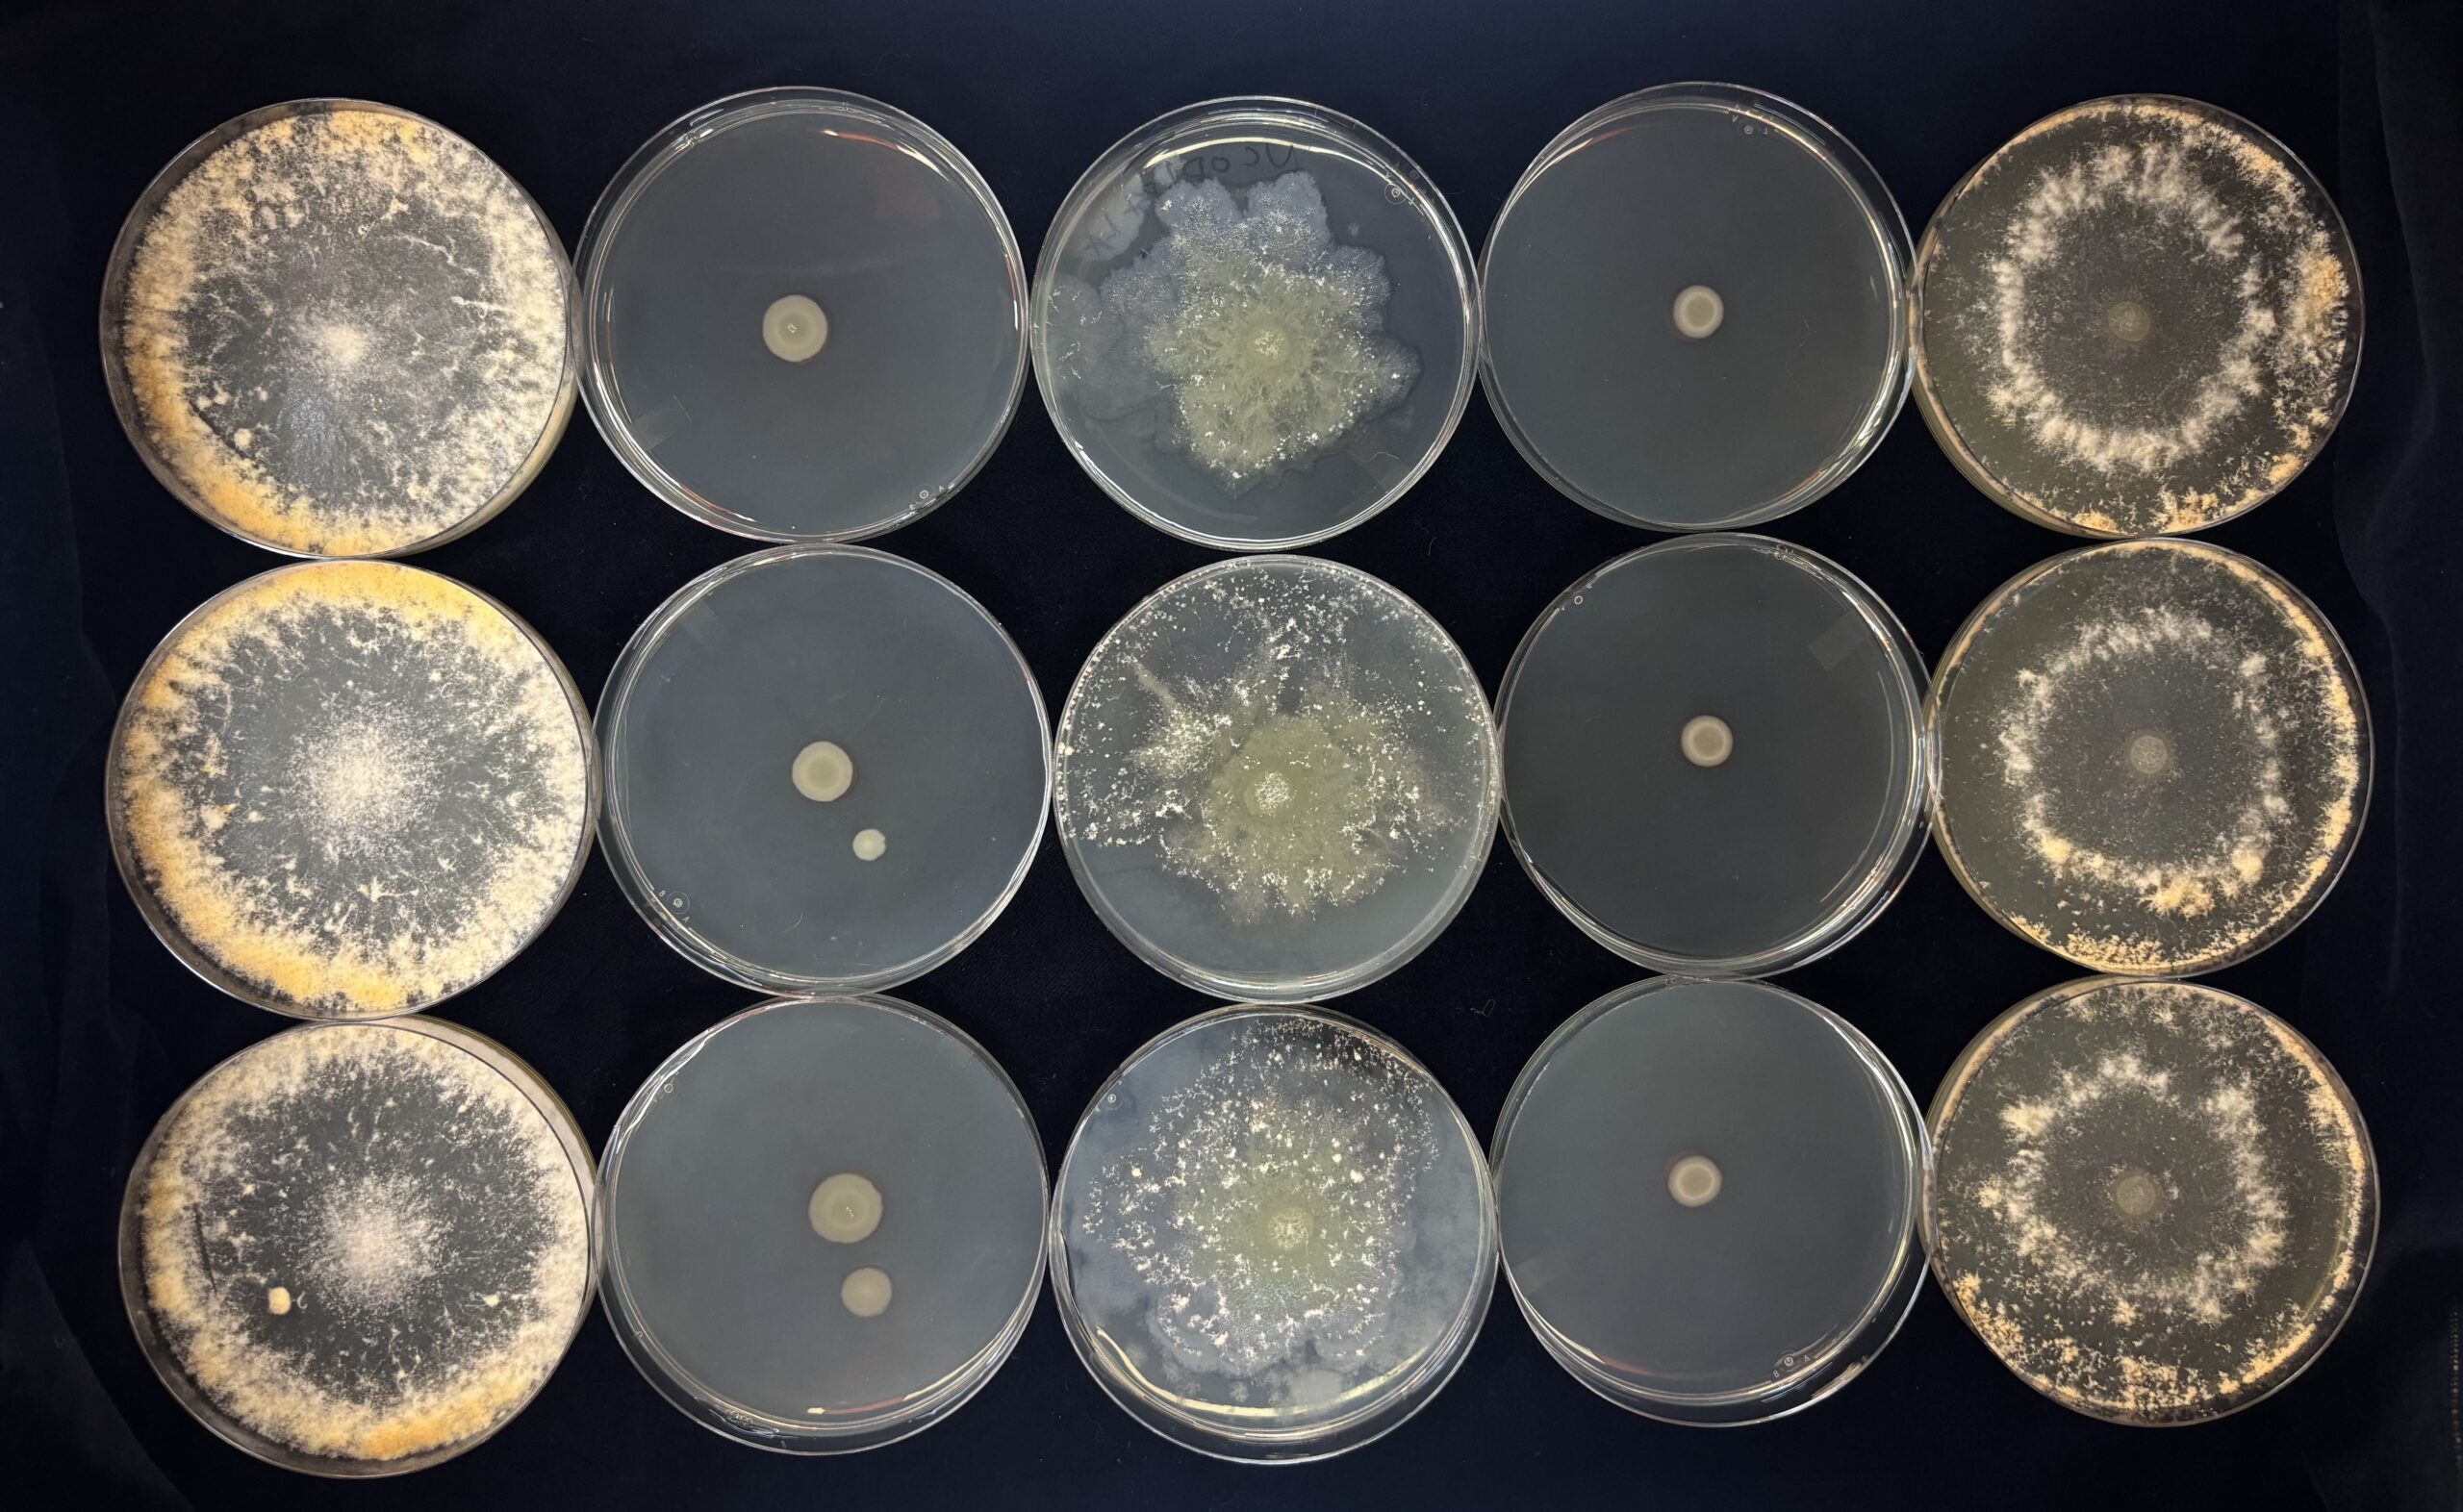

Krasileva Lab
Full description of lab culture - seeĀ Krasileva Lab Charter
231 Koshland Hall, Berkeley CA 94720 kseniak [at] berkeley.edu.
Lab News
October 2025
New preprint! š±š»
Wei W, Wu X, Sutherland CA, Lin Y, Lunde C, Exposito-Alonso M, Krasileva K. Natural variation in regulatory code revealed through Bayesian analysis of plant pan-genomes and pan-transcriptomes. bioRxiv [Preprint]. 2025 Oct 28:2025.10.27.684862. doi: 10.1101/2025.10.27.684862. PMID: 41280085; PMCID: PMC12636352.
September 2025
Graduate student Nicole Dubs has been award the prestigious Center for Computational Biology NIH T32 fellowship! š„š»
New preprint: The Annotated Blueprint: Integrated Functional Genomic Resources for a model Tetraploid Wheat Triticum turgidum cv. Kronos
July 2025
New preprint from the lab! šš»
Stevens DM, Yang D, Liang TJ, Li T, Vega B, Coaker G, Krasileva K. Mamp-ml: A deep learning approach to epitope immunogenicity in plants. bioRxiv [Preprint]. 2025. doi: 10.1101/2025.07.11.664399
This work has been presented at International Congress for Molecular Plant Microbe Interactions in Cologne July 2025 and will be presented in September 2025 at the Machine Learning for Computational Biology in New York. Link to recording on YouTube.
If you are in industry and want to use mamp-ml, get in touch: dmstev@berkeley.edu, kseniak@berkeley.edu
February 2025
Frances Grace Stark's work on establishing molecular system to study fungal-bacterial interactions with two model organisms, Neurospora crassa - Pseudomonas syringae and its application to discover fungal genes required for growth in the presence of bacteria is now available on bioRxiv
Stark FG, Torii-Karch M, Yuvaraj S, Bonometti L, Gladieux P, Glass NL, Krasileva K. Molecular Insights into Fungal Innate Immunity Using the Neurospora crassa - Pseudomonas syringae Model. bioRxiv [Preprint]. 2025 Jan 24:2025.01.22.633611. doi: 10.1101/2025.01.22.633611
Past talks (recorded)
Scientific conferences and seminars
Ksenia Krasileva - The Rise of Resistance: Natural Diversity Informs Rational Modifications of Plant Immune Receptors (and also exploration of fungal immune system) - invited seminar at MPI, Tubingen - link to recording (1 hr)
Ksenia Krasileva - Evolution in Overdrive: Decoding and Encoding Genomes for Disease Resistance - Saclay Plant Science Hub invited seminar Oct 2024 - link to recording (40 min)
Chandler Sutherland - "Contributions of Mutation and Selection to the Rapid Evolution of Plant Innate Immune Receptors" - Biology of Genomes 2024 - link to recording (15 min talk plus Q&A)
Pierre Joubert - "Catching up to Fungal Plant Pathogens" - Pierre Joubert Dissertation Finishing Talk, May 15, 2023 - link to recording (1 hr seminar)
Kyungyong Seong -Ā "Elucidating effector evolution through predicted structures"Ā MPMI Virtual Seminar - Best MPMI Graduate Student Paper Award - link to recordingĀ (30 min seminar plus Q&A)
Ksenia - "Comparative structural genomics of pathogen effectors and plant immune receptors:Ā from natural diversity to precise modification" UC Riverside, Sept 30th, invited seminar - link to recordingĀ Ā (1 hr seminar)
Pierre Joubert - "Characterizing the extrachromosomal circular DNAs of Magnaporthe oryzae and their potential role in adaptation"Ā - The 31st Fungal Genetics Conference, March 15-20 2022 - link to recordingĀ (15 min talk)
Erin Baggs - "Lessons from loss; plant immune signaling pathways and pathogen interactionsĀ from land to water" - PhD finishing talk, January 13th - link to recording (46 min seminar with intro by Ksenia)
Outreach
Chandler Sutherland - "How Plants Evolve Their Immune System" The Graduates radio podcast, hosted on on KALX 90.7 link to recording
Chandler Sutherland - "It's Not Easy Staying Green:Ā Understanding Plant Immune Systems" Ask a Science Envoy, hosted by Wonderfest: Bay Area Beacon of Science.Ā " link to recording
Fraces (Grace) Stark - "Fungal Immune Systems with Grace Stark" - Central Texas Mycological Society, Nov 18th 2021 7-9PM CTĀ invited talk. Open to public with livestream on Youtube - link to recordingĀ (~1 hr 30 min with discussion)
Who we are and what we do
Krasileva lab an inter-disciplinary group of people.Ā Our common goal is to understand innate immunity; currently we are working with plants and fungi. We focus on evolution and function of immune genes, as well as the mechanisms that regulate genetic diversity. To read more about specific research projects visit About us and Publications.
The lab is located in Koshland Hall, we are part ofĀ Department of Plant and Microbial BiologyĀ as well as the Innovative Genomics Institute and The Center for Computational Biology at the University of California Berkeley.
If you are interested in joining the lab:
Undergraduate research: reach out to us directly before the semester begins or look for projects at URAP and SPUR.
Graduate students: we are part ofĀ graduate programs in Microbiology and Plant BiologyĀ as well as Center for Computational Biology. To discuss aĀ rotation, please reach out a few weeks in advance.
Postdocs: please send Ksenia your CV and a list ofĀ postdoc fellowships you would like to apply for.
Staff: occassionally, positions become available. Please, watch this space or send us a note.
Our lab culture, summarized in the Krasileva Lab Charter,Ā is built on honesty and transparency and open communication. We aim to maintain the highest quality of research and strongest work ethic without sacrificing our health or wellbeing of our families.Ā If you have any questions about Krasileva Lab, do not hesitate to reach out to any lab members.